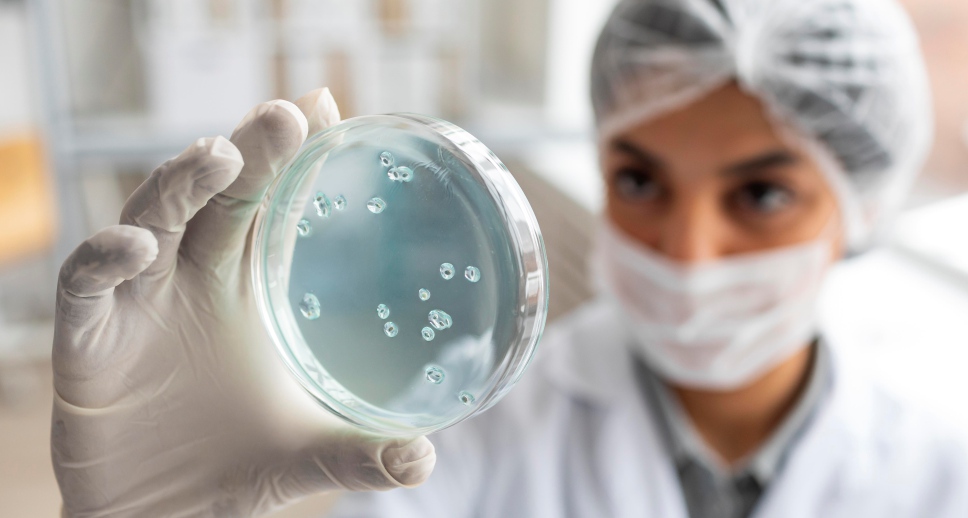

business with online Courses
with biowise
without barriers
fellow Key Opinion Leaders
online Bio Course?
with biowise
Explore Our Courses
Competent Authority Update on Preparing for IVDR Clinical Performance Study Applications

Critical Considerations in Site Selection and Subject Enrollment in Device and IVD Clinical Studies

Competent Authority Expectations and Management of Device Clinical Study Applications Under the MDR

Developing Clinical Investigation and Performance Study Plans That Meet Regulatory and Operational Requirements

General Data Protection Regulations in the EU

Clinical Investigations According to ISO-14155-2020 – Useful Methods for Effective Implementation

Aligning Clinical Investigations and Risk Management to Ensure MDR Compliance

MDR Requirements for Sponsor GCP Inspections (audits) and How to Conduct Them

Standards, Harmonisation Process and Common Specifications

General Safety and Performance Requirements under the Medical Devices

Software, Artificial Intelligence and Cybersecurity in the European Union

Issues Arising from the Implementation of the IVD-Regulations

Clinical Evaluation, Investigations and PMCF under MDR

Major Regulatory Compliance Challenges for the Non-European Industry

Benefit Risk Assessment

Enhance your knowledge
Choose your expertly designed course
Our Channels
Biowise delivers you updated online courses in most of the bio fields: Medical devices, pharma, cosmetics, clinical trials, cannabis, Diagnostics and more
Medical Devices
Clinical Trials
Pharma
Diagnostics
Our Lecturers
Access courses 24/7 & learn from our experts in the industry
biowise specializes in providing comprehensive information and updates in all areas of Bio-medical, through courses and lectures on demand.
Our Mission

Our Vision
Our vision is to help disseminate cutting-edge knowledge for the international biotech and biomed community by providing a superior platform from which Key Opinion Leaders are able to guide the decision-makers through the myriad of information.
biowise is at the frontline of Sharing Medical Knowledge through informative, sharp, high quality courses.

Our Values
Biowise values your time and opinion which is why we initiated Biowise to facilitate the evaluation of new ideas and new research in a creative, engaging setting which promotes active dialogue between industry and professionals from the biomedical arena.











